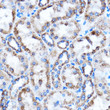
Immunohistochemistry analysis of paraffin-embedded Rat kidney using CTGF rabbit polyclonal antibody (STJ113799) at dilution of 1:100 (40x lens). Perform microwave antigen retrieval with 10 mM PBS buffer pH 7. 2 before commencing with immunohistochemistry staining protocol.

Anti-CTGF antibody (100-200) (STJ113799)
SPECIFICATIONS
ClonalityPolyclonal
HostRabbit
ConjugationUnconjugated
IsotypeIgG
General Information
| Short Description | Rabbit polyclonal CTGF (100-200) antibody for use in WB, IHC-P, IF, ICC and ELISA in human, mouse and rat samples. Datasheet included with dilution recommendations, and related reagents. |
| Applications | WB/IHC-P/IF/ICC/ELISA |
| Host | Rabbit |
| Reactivity | Human/Mouse/Rat |
| Note | STRICTLY FOR FURTHER SCIENTIFIC RESEARCH USE ONLY (RUO). MUST NOT TO BE USED IN DIAGNOSTIC OR THERAPEUTIC APPLICATIONS. |
Product Properties
| Clonality | Polyclonal |
| Isotype | IgG |
| Conjugation | Unconjugated |
| Concentration | Lot specific |
| Purification | Affinity purification |
| Dilution Range | WB:1:500-1:1000IHC-P:1:50-1:200IF/ICC:1:50-1:200ELISA:Recommended starting concentration is 1 Mu g/mL. Please optimize the concentration based on your specific assay requirements. |
| Formulation | PBS with 0.05% Proclin300, 50% Glycerol, pH 7.3. |
| Storage Instruction | Store at-20°C for up to 1 year from the date of receipt, and avoid repeat freeze-thaw cycles. |
Target Information
| Gene Symbol | CCN2 |
| Gene ID | 1490 |
| Uniprot ID | CCN2_HUMAN |
| Immunogen Region | 100-200 |
| Immunogen Sequence | GAPCIFGGTVYRSGESFQSS CKYQCTCLDGAVGCMPLCSM DVRLPSPDCPFPRRVKLPGK CCEEWVCDEPKDQTVVGPAL AAYRLEDTFGPDPTMIRANC L |
| Specificity | A synthetic peptide corresponding to a sequence within amino acids 100-200 of human CTGF (NP_001892.2). |
Additional Info
| Tissue Specificity | Expressed in bone marrow and thymic cells. Also expressed one of two Wilms tumors tested. |
| Function | Major connective tissue mitoattractant secreted by vascular endothelial cells. Promotes proliferation and differentiation of chondrocytes. Is involved in the stimulation of osteoblast differentiation and has a critical role in osteogenesis. Mediates heparin- and divalent cation-dependent cell adhesion in many cell types including fibroblasts, myofibroblasts, endothelial and epithelial cells. Enhances fibroblast growth factor-induced DNA synthesis. |
| Protein Name | Ccn Family Member 2Cellular Communication Network Factor 2Connective Tissue Growth FactorHypertrophic Chondrocyte-Specific Protein 24Insulin-Like Growth Factor-Binding Protein 8Ibp-8Igf-Binding Protein 8Igfbp-8 |
| Database Links | Reactome: R-HSA-2032785Reactome: R-HSA-8951671 |
| Cellular Localisation | SecretedExtracellular SpaceExtracellular Matrix |
| Alternative Antibody Names | Anti-Ccn Family Member 2 antibodyAnti-Cellular Communication Network Factor 2 antibodyAnti-Connective Tissue Growth Factor antibodyAnti-Hypertrophic Chondrocyte-Specific Protein 24 antibodyAnti-Insulin-Like Growth Factor-Binding Protein 8 antibodyAnti-Ibp-8 antibodyAnti-Igf-Binding Protein 8 antibodyAnti-Igfbp-8 antibodyAnti-CCN2 antibodyAnti-CTGF antibodyAnti-HCS24 antibodyAnti-IGFBP8 antibody |
Information sourced from Uniprot.org